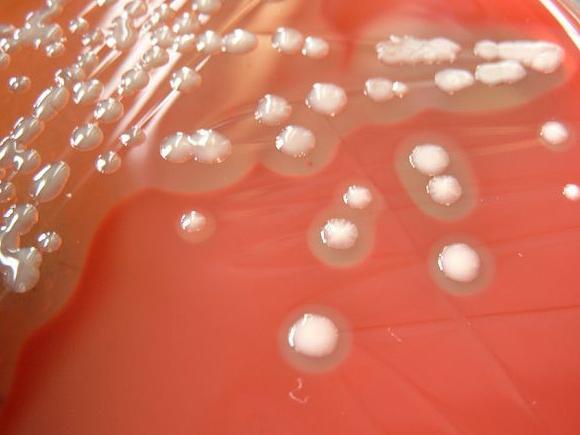
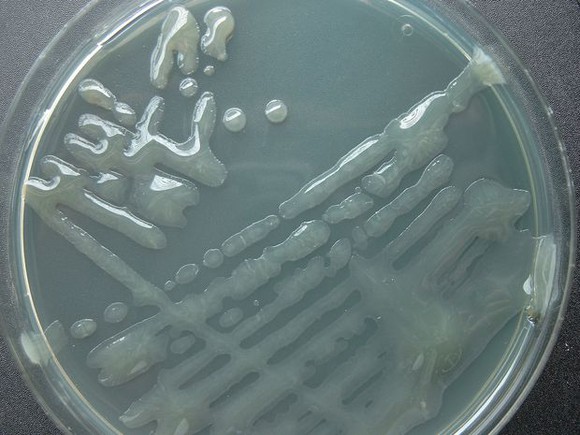
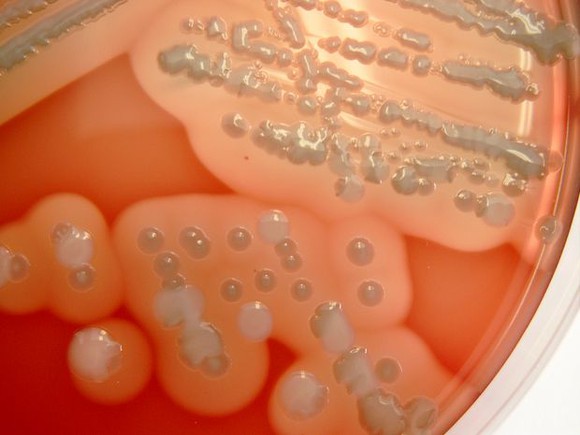
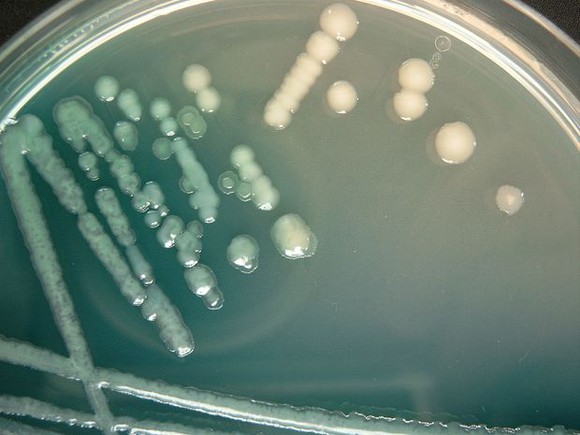

Sie führen bei CF-Patienten zu einer schnell fortschreitenden Verschlechterung der Lungenfunktion. Eine standardisierte und qualitätsorientierte Mukoviszidosediagnostik stellt hohe Ansprüche an das Laborpersonal.
Erregeridentifizierung
S. aureus
S. aureus verdächtige Kolonien (weißliche bis goldgelbe Pigmentierung und ß-Hämolyse) werden zunächst mit kommerziellen Objektträger-Aglutinationsteste der 3. Generation überprüft. Ein positives Ergebnis sollte durch den Nachweis freier Koagulase im Röhrchentest oder mit einem kommerziellen biochemischen Testsystem bestätigt werden. Da der Respirationstrakt der CF-Patienten gleichzeitig mit verschiedenen S. aureus-Klonen, die z.T. Unterschiede im Resistenzverhalten aufweisen können, kolonisiert oder infiziert sein kann, müssen unterschiedliche Morphotypen (pigmentiert, unpigmentiert, mit und ohne Hämolyse, Größenunterschiede) differenziert werden.
Bei zweifelhaften Ergebnissen oder bei weiter bestehendem Verdacht auf das Vorliegen von S. aureus kann u. a. eine Identifi- zierung mittels MALDI-TOF zum Ergebnis führen.
S. aureus-SCVs sind sowohl in der Morphologie als auch biochemisch so verändert, dass mit den herkömmlichen Identifizierungsmethoden oft keine eindeutige Identifizierung möglich ist. Eine Spezies-Identifizierung ist oft erst mit dem kommerziell erhältlichen Accuprobe DNA-Sonden-Test möglich (Abb. 1).

Abb. 1: Flussdiagramm zur Identifi zierung von S. aureus
P. aeruginosa
Eine vereinfachte Identifizierung von P. aeruginosa ist möglich aufgrund folgender typischer kultureller Artmerkmale:
■ Wachstum auf Schafblutagar mit flachen z.T. mucoide unscharf begrenzten Kolonien mit ß-Hämolyse, deren Oberfläche durch Pyocyaninbildung oft metallisch glänzt. Auffallend ist ein süßlich-aromatischer Geruch.
■ Blaugrüner Pyocyanin-Nachweis auf P-Agar
■ Wachstum bei 42° C auf Cetrimid-Agar.
Mukoide Oxidase-positive Bakterien können bei Empfindlichkeit gegenüber Polymycin i.d.R. als P. aeruginosa identifiziert werden (Abb. 3a - 3d).
Untypische P. aeruginosa-Morphotypen müssen biochemisch mit kommerziell erhältlichen manuellen oder automatisierten Systemen identifiziert werden. Zweifelhafte Ergebnisse sollten durch molekulardiagnostische Verfahren wie MALDI-TOF-Analyse oder Gensequenzierung abgeklärt werden (Abb. 2).

Abb. 2: Flussdiagramm zur Identifizierung von P. aeruginosa und anderen CF-typischen Nonfermentern
Im mikrobiologischen Befund soll stets nach nonmukoid und mukoid differenziert werden.
B. cepacia-Komplex
Die Differenzierung von Spezies innerhalb des B. cepacia-Komplexes ist schwierig. Mit biochemischen Differenzierungsmethoden ist keine Spezies-Bestimmung möglich. Auch mit der MALDI- TOF Technologie ist eine zuverlässige Spezies-Identifizierung oft nicht möglich. Zur sicheren Spezies-Differenzierung sollten Isolate aus dem B. cepacia-Komplex an ein Konsiliarlabor für Mukoviszidose-Bakteriologie eingeschickt werden.
S. maltophilia und andere Nonfermenter
S. maltophilia und die sichere Identifizierung Oxidase-positiver Nonfermenter und ihre Abgrenzung gegenüber untypischen P. aeruginosa-Varianten ist mit biochemischen Nachweismethoden, wie kommerziellen „Bunte Reihen“ (Api-System) oder automatisierten Verfahren (VITEK 2, Phoenix oder Walk-Away), möglich. Aufgrund der ständig aktualisierten Datenbanken der automatisierten Geräte, liefern diese bei der Identifizierung von Nonfermentern bis auf wenige Ausnahmen zuverlässigere und bessere Ergebnisse als konventionelle biochemische Verfahren. Alternativ kann eine Identifizierung mittels MALDI-TOF-Analyse oder anderer molekularer Methoden erfolgen.
Empfindlichkeitsprüfung
Die Resistenztestung von CF-Isolaten stellt eine besondere Herausforderung an das mikrobiologische Labor. Das Erregerspektrum mit häufig multiresistenten Nonfermentern wie P. aeruginosa, Keime des B. cepacia-Komplexes, S. maltophilia, A. xylosoxidans u. a. sowie die Selektion langsam wachsender Morphotypen erschweren die Reproduzierbarkeit einer genauen Empfindlichkeitstestung. Die mit in-vitro-Verfahren ermittelten Grenzwerte sind nur eingeschränkt auf die in-vivo-Verhältnisse übertragbar. Die Ursachen hierfür sind vielfältig, zu nennen sind z.B. veränderte Pharmakokinetik, stark visköses Lungensekret, Biofilmbildung der Infektionserreger. Als Hauptursache der oft unzureichenden klinischen Wirksamkeit der Antibiotika bei CF-Patienten wird das intrapulmonale Wachstum der bakteriellen Infektionserreger in Biofilmen angesehen. Therapieversagen bei mutmaßlich sensiblen P. aeruginosa-Stämmen wird beobachtet. Umgekehrt konnten Studien zeigen, dass CF-Patienten bei vermeintlich resistenten P. aeruginosa-Stämmen nach Antibiotikatherapie eine deutliche Verbesserung der Lungenfunktion aufwiesen. Werden von ein und demselben Bakterium unterschiedliche Morphotypen kultiviert, muss von jedem Morphotyp getrennt eine Resistenzbestimmung durchgeführt werden.
MRSA-Isolate sind gegenüber allen Betalaktamantibiotika resistent. Eine zunehmende Resistenzentwicklung gegenüber Linezoid wird beobachtet.
Abb. 3a: Nicht pigmentierte mucoide Kolonien von P. aeruginosa auf Columbia-Blutagar
Abb. 3b: Pyocyanin-bildende mucoide Kolonien von P. aeruginosa auf Pseudosel-Agar
Methoden zur Empfindlichkeitsprüfung
Als Methode der Wahl zur Empfindlichkeitsprüfung gilt die MHK-Bestimmung mittels Mikrodilution, sie ist arbeits- und zeitaufwendig. Diese Methode sollte insbesondere zur Empfindlichkeitsprüfung anspruchsvoller Erreger wie S. maltophilia und bei Erregern des B. cepacia-Komplexes gewählt werden. Damit die Ergebnisse eindeutig ablesbar sind, erfordert die Empfindlichkeitstestung von CF-Isolaten häufig längere Bebrütungszeiten von bis zu 48 Stunden.
Im Gegensatz dazu ist die MHK-Bestimmung mittels Gradientendiffusion mit dem E-Test leicht und schnell durchführbar und korreliert gut mit der Referenzmethode.
Die Empfindlichkeitstestung von P. aeruginosa mittels Agardiffusion zeigt eine gute Übereinstimmung mit der Mikrodilution bei der Testung nonmukoider Stämme. Sie wird mit Ausnahme der Testung von Colistin als zuverlässig beurteilt und gilt als akzeptabel für die Routinetestung von P. aeruginosa. Die Testung von Colistin sollte immer mittels MHK-Bestimmung erfolgen. Mukoide Stämme liefern keine verwertbaren Ergebnisse zur Therapie.
Die Anwendung von automatisierten Geräten zur Empfindlichkeitstestung von P. aeruginosa und anderen Nonfermentern ist nicht immer zuverlässig, bedingt durch verzögertes Wachstum der Bakterien, mukoide Isolate oder seltene Nonfermenter.
Unter Berücksichtigung klinischer Aspekte sollte von allen potenziell pathogenen Erregern einschließlich aller Morphotypen von P. aeruginosa wahlweise mit der manuellen MHK-Bestimmung (Mikrodilution), die Gradientendiffusion (E-Test) oder der Agardiffusion eine Empfindlichkeitsprüfung durchgeführt werden. Die standardisierte Testung erfolgt i.d.R. nach den Empfehlungen der EUCAST (European Committee on Antimicrobial Susceptibility Testing) oder der CLSI (Clinical Laboratory and Standards Institute).
Abb. 3c: Phänotypische Pyocyanin-bildende Varianten von P. aeruginosa auf Columbia-Blutagar
Abb. 3d: Phänotypische Varianten mit und ohne Pyocyanin-Bildung von P. aeruginosa auf Pseudosel-Agar
Antibiotika
Folgende Antibiotika werden für die in-vitro-Resistenztestung für P. aeruginosa empfohlen.
Erste Wahl: Piperacillin, Ceftazidim, Meropenem, Tobramycin, Ciprofloxacin, Colistin.
Alternativ: Piperacillin-Tazobactam, Cefepime, Gentamicin, Amikacin, Aztreonam, Fosfomycin, Doripenem.
Kombinationstestung
Multiresistente Stämme von P. aeruginosa, S. maltophilia und Burkholderia spp. stellen ein existenzielles Problem bei CF-Patienten dar. Zur Behandlung wird oft eine Mehrfachtherapie mit zwei oder drei unterschiedlichen Antibiotika durchgeführt. Unbekannt ist jedoch dabei, ob synergistische, additive oder antagonistische Effekte auftreten. Die Synergie-Testung kann in Form einer Kombinationstestung mit dem sehr aufwendigen Checkerboard- Verfahren durchgeführt werden (Schachbrett-Titration) oder mittels kombinierter E-Test-Streifen. Mit dem E-Test lassen sich individuell auf den einzelnen Patienten bezogene Kombinationstestungen relativ schnell durchführen.
Die Ergebnisse einer in-vitro-durchgeführten Kombinationstestung sind jedoch nur eingeschränkt auf die Verhältnisse bei CF-Patienten übertragbar. Sie haben nur geringen Nutzen für den klinischen Erfolg und sind daher i.d.R. nicht zu empfehlen.
Antikörpernachweis
Während die Eliminierung von P. aeruginosa aus dem Respirationstrakt von CF-Patienten im Fall einer chronischen Kolonisation und Infektion i.d.R. nicht mehr gelingt, kann durch eine frühzeitig eingeleitete Therapie bei einem P. aeruginosa-Erstnachweis ein chronisches Infektionsstadium verhindert werden. Ein wesentliches Ziel ist es daher, eine Kolonisation mit P. aeruginosa so früh wie möglich nachzuweisen. Umso größer ist die Chance einer Eradikation, bevor es zu einer chronischen Infektion durch P. aeruginosa kommt.
Der Nachweis von Antikörpern im Serum kann häufig schon zu einem Zeitpunkt erfolgen, wenn in den respiratorischen Proben noch kein P. aeruginosa nachweisbar ist.
Ab dem 10./11. Lebensjahr sollten alle CF-Patienten ohne kulturellen Nachweis von P. aeruginosa einmal jährlich auf Antikörper untersucht werden. Ein Nachweis von P. aeruginosa-Antikörpern ist auch ohne positive Kultur ein Hinweis für eine Besiedlung mit P. aeruginosa und kann ohne mikrobiologischen Erregernachweis eine Therapie rechtfertigen. Bei Patienten, die mit P. aeruginosa dauerbesiedelt sind, hat die Bestimmung der P. aeruginosa-Antikörper keinen Sinn.
ELISA-Antikörpertest
Der einzige in Deutschland kommerziell erhältliche Test ist ein ELISA-Antikörpertest, dieser ermöglicht die Bestimmung von 3 wichtigen extrazellulären Virulenzfaktoren von P. aeruginosa der alkalischen Protease, Elastase und dem Exotoxin A, die hochgradig immunogen sind und von fast allen P. aeruginosa-Stämmen exprimiert werden. Cut-off Werte werden wie folgt festgelegt:
■ Ein Ergebnis gilt als positiv, wenn einer der Antikörper ≥ 500 liegt.
■ Ein negatives Ergebnis liegt vor, wenn alle 3 Antikörpertiter unter 500 liegen.
Nach erfolgter Eradikationstherapie sollte nach 3 Monaten eine Antikörperkontrolle erfolgen, danach dann einmal jährlich.
Nicht-tuberkulöse Mykobakterien
Als Nicht-tuberkulöse Mykobakterien (NTM) werden Mykobakterien bezeichnet, die nicht zu den Erregern des M. tuberculosis- Komplex gehören. Da sie frei in der Umwelt vorkommen, werden sie auch potenziell pathogene Umwelt (environmental) Mykobakterien genannt. Es sind über hundert NTM-Arten bekannt, davon wurden bisher ca. die Hälfte aus klinischem Untersuchungsmaterial isoliert. Die meisten NTM sind apathogen, ein relativ geringer Anteil der bisher bekannten Arten ist obligat oder fakultativ pathogen. Zumeist begünstigen Grunderkrankungen wie z.B. die Cystische Fibrose eine NTM-Infektion.
Erregerreservoir
Nicht-tuberkulöse Mykobakterien sind ubiquitär weit verbreitet. Sie sind nicht nur gegen Temperatur- und pH-Schwankungen, sondern auch gegen Chlor resistent und können daher auch in Wasserleitungen und Warmwassersystemen vorkommen, in denen sie einen Biofilm bilden. Im Trinkwasser können u.a. M. gordonae, M. chelonae, M. fortuitum, M. flavescens und auch M. avium isoliert werden. Die im Englischen unter dem Namen „tap water bacillus“ bekannte apathogene Spezies M. gordonae ist im Trinkwasser das am häufigsten nachweisbare Mykobakterium. Einige NTM sind in der Lage, sich im aufbereiteten destillierten Wasser zu vermehren. Die NTM lassen sich nur schwer aus kontaminierten Leitungswassersystemen eliminieren, wodurch sie in Krankenhäusern in Nasszellen, Luftbefeuchtern und Endoskopiewaschmaschinen eine erhebliche Gefahr darstellen. Auch physiologische NaCl-Lösungen können mit NTM besiedelt sein. Als weitere Infektionsquellen können Klimaanlagen, Therapiebecken, Swimmingpools, Whirlpools infrage kommen. Aus Erdproben werden u.a. M. avium, M. fortuitum und M. kansasii isoliert.
Durch Reinigung mit Wasser können Lebensmittel mit NTM kontaminiert sein. Vögel, Haustiere, Nutztiere sind weitere Erregerreservoire z.B. für M. avium und M. simiae. Durch diese weite Verbreitung kommen viele Menschen mit NTM in Kontakt ohne jedoch zu erkranken. Die Infektion erfolgt vorwiegend aerogen, über kontaminiertes Wasser, Gegenstände oder Nahrungsmittel.
Bisher hielt man eine direkte Übertragung von NTM von Mensch zu Mensch in der Regel für nicht möglich. Nach neueren Erkenntnissen muss jedoch mit einem Übertragungsrisiko von NTM, z.B. in CF-Ambulanz, als wahrscheinliche Infektionsursache gerechnet werden. Das mögliche Übertragungsrisiko für NTM dürfte jedoch deutlich niedriger einzuschätzen sein, als dasjenige für B. cepacia oder für Methicillin-resistente S. aureus.
Infektionserreger ja oder nein?
Da NTM in der Umwelt allgegenwärtig sind, kann es leicht zur Kontamination von Untersuchungsmaterial kommen. Aufgrund ihrer fakultativen Pathogenität sagt ein einmaliger Nachweis noch nichts über ihre klinische Bedeutung aus, auch wenn unterstellt wird, dass der isolierte Keim zu den NTM zählt, die als potenzielle Krankheitserreger in Frage kommen können. Nur entsprechende klinische Symptomatik in Verbindung mit röntgenologischem Befund und dreimaligem Nachweis derselben NTM-Spezies aus Sputum bzw. bronchoalveolärer Lavage oder der einmalige Nachweis von NTM aus Biopsien liefern den gesicherten Beweis für die Diagnostik einer NTM-Infektion. Nur eine einzige positive Untersuchungsprobe bei fehlenden klinischen Anzeichen spricht für eine Kolonisation oder Kontamination.
Klinik der Nicht-tuberkulösen Mykobakterien
Neben pulmonalen Erkrankungen können vorwiegend noch Lymphadenitiden insbesondere bei Kindern, granulomatöse Hautveränderungen und disseminierte Infektionen diagnostiziert werden. Respiratorische Erkrankungen sind die häufigsten lokalisierten Manifestationsformen der Infektion mit NTM. Die Infektionen erfolgen vorwiegend aerogen. Die klinische Symptomatik entspricht der der Tuberkulose in abgeschwächter Form mit über Wochen bis Monate anhaltendem Husten, Auswurf, subfebriler Temperatur, Abgeschlagenheit, Nachtschweiß und Gewichtsabnahme sind seltener.
Diagnostik
Zur Absicherung der Diagnose einer Mykobakteriose bedarf es in jedem Fall des mikrobiologischen Nachweises bis zur Spezies- Identifizierung. Die Kultivierung von NTM besagt nicht, dass eine relevante Infektion vorliegt. Jedes Isolat NTM muss kritisch beurteilt werden, ob eine Infektion, eine Kolonisation oder eine Kontamination vorliegt. Ob es sich bei einem Isolat um einen Krankheitserreger handelt, kann nur im Zusammenhang mit der Anamnese des Patienten, der klinischen Symptomatik und eventuell der radiologischen Diagnostik festgestellt werden. CF-Patienten sollten 1- bis 2-mal pro Jahr auf NTM untersucht werden.
Untersuchungsmaterial
Bei pulmonalen Untersuchungsproben kann anhand nur einer Untersuchungsprobe keine sichere Entscheidung getroffen werden, ob eine Infektion oder nur eine Kontamination vorliegt. Zur Abklärung einer Infektion mit NTM sollten bis zu 5 Sputumproben auf Mykobakterien untersucht werden.
Vorbehandlung der Proben
Die in Untersuchungsproben neben den Mykobakterien vorhandenen Begleitkeime müssen abgetötet werden, da sie aufgrund ihrer wesentlich kürzeren Generationszeit die langsam wachsenden NTM überwuchern würden. Zusätzlich zur Abtötung störender Begleitkeime müssen zähflüssige und schleimige Materialproben homogenisiert und eine Anreicherung der Mykobakterien durch Zentrifugation erreicht werden. Bewährt hat sich die Vorbehandlungsmethode mit N-Acetyl-L-Cystein (Homogenisierung) und 1n NaOH zur Abtötung der Begleitflora. Da in Proben des Respirationstraktes bei CF-Patienten häufig P. aeruginosa und weitere schnell wachsende Bakterien in hoher Keimzahl anzutreffen sind, ist die Dekontamination limitiert.
Direktnachweis
Zum Direktnachweis der NTM aus Untersuchungsmaterial ist die Mikroskopie mit der Ziehl-Neelsen- und Fluoreszenz-Färbung mit Auramin das schnellste und preisgünstigste Verfahren, das aber keine Identifizierung auf Speziesebene erlaubt. Zudem ist der mikroskopische Nachweis wenig sensitiv. Es müssen zwischen 104 bis 105/ml Keime in der Probe enthalten sein, um NTM mikroskopisch zu erfassen. Diese mangelnde Sensitivität führt dazu, dass in nur 30 % bis 40 % der später positiv werdenden Kulturen die NTM erfasst werden.
Nukleinsäure-Amplifikations-Techniken (NAT) zum direkten Nachweis von NTM sind erhältlich, finden aber bisher kaum Anwendung. Das Mukoviszidosezentrum am Klinikum Essen, das zu den größeren Zentren Deutschlands gehört, führt nur den mikroskopischen Direktnachweis durch.
Kultureller Nachweis
Zum kulturellen Nachweis von NTM sollten pro Untersuchungsprobe zwei unterschiedliche feste Kulturmedien, z.B. ein Löwentein- Jensen-Medium zur Beurteilung der Koloniemorphologie und ein Stonebrink-Medium mit Antibiotikazusatz (z.B. Colistin, Polymycin B) beimpft werden, zusätzlich ein flüssiges Kulturmedium, das zu einem besseren und schnelleren Wachstum der NTM führt, allerdings eher zu Verunreinigung neigt. Bewährt hat sich die Verwendung einer modifizierten mit Wachstumsupplement angereicherten 7H9Bouillon nach Middlebrook.
Die festen Kulturmedien werden bei 30° C und 36° C bis zu 8 Wochen, Flüssigkulturen bis zu 6 Wochen bebrütet.
Die besten Ergebnisse werden mit der automatisierten Flüssigkultur erzielt. Das Prinzip der Systeme besteht im Nachweis von Stoffwechselleistungen der Mykobakterien in Flüssigkulturen, die entweder fluoremetrisch oder kolonimetrisch nachgewiesen werden. Durch den Einsatz verschiedener, kommerziell erhältlicher Flüssigsysteme werden nicht nur der Arbeitsaufwand verringert und die Sensitivität erhöht, sondern die Detektionszeit wird entschieden verkürzt. Sie liegt bei NTM bei durchschnittlich 7 bis 10 Tagen. Nachteile sind erhöhte Kontaminationsraten und Mischkulturen können nur unter erhöhtem Arbeitsaufwand erfasst werden.
Zeigt sich Wachstum in der Flüssigkultur müssen zur Kontrolle, ob säurefeste Stäbchen nachweisbar sind und eine Rein- oder Mischkultur vorliegt, ein Ziehl-Neelsen- und ein Grampräparat angefertigt werden. Bei Vorhandensein von Begleitflora z.B. P. aeruginosa kann durch Zusatz von Oxalsäure diese weitgehend eliminiert werden.
Identifizierung und Differenzierung
Die häufigsten bei CF-Patienten nachgewiesenen NTM sind Spezies aus dem M. avium-Komplex und M. abscessus mit den Subtypen M. abscessus spp. abscessus, M. abscessus spp. massiliense und M. abscessus spp. bolletii. Im letzten Jahrzehnt wurden weltweit deutliche Zunahmen in der Infektionshäufigkeit mit M. abscessus beobachtet. Vorwiegend Infektionen mit M. abscessus spp. massiliense führen bei CF-Patienten zu einer schnell fortschreitenden Verschlechterung der Lungenfunktion, die aufgrund der Multiresistenz schwer zu behandeln ist.
Für die Feststellung einer behandlungsbedürftigen Erkrankung mit NTM ist eine Spezies-Identifizierung und -Differenzierung der kultivierten säurefesten Stäbchen erforderlich. Darüber hinaus ist die Differenzierung zwischen verschiedenen NTM für die Therapieplanung von entscheidender Bedeutung, da diese je nach Spezies gegen unterschiedliche Antibiotika resistent sein können. Die kultivierten säurefesten Stäbchen können mit kommerziell erhältlichen Testkits z.B. AccuProbe (Fa. bioMérieux), ProbeTec (Fa. BD Diagnostic), GenoType Mycobacteria CM/AS identifiziert werden.
GenoType Mycobacterium CM-Test
GenoType Mycobacterium AS-Test
Mit den beiden Testsystemen GenoType Mycobacterium CM und AS (Fa. Hain Lifescience) können zirka 40 der klinisch relevanten NTM-Spezies einschließlich des M. tuberculosis-Komplexes identifiziert werden. Die Teste basieren auf der bewährten DNA-Strip-Technologie.
Mykobakterielle DNA wird aus dem Kulturmaterial isoliert, mittels PCR spezifisch vervielfältigt und über eine reverse Hybridisierung und eine enzymatische Farbreaktion auf einem Membranstreifen detektiert. Durch die Möglichkeit einer manuellen oder automatisierten Durchführung ist die Methode individuell an die jeweilige Anzahl der zu differenzierenden Proben adaptierbar und somit eine ökonomisch sinnvolle Alternative.
Empfindlichkeitstestung
Für die NTM gibt es noch keine standardisierte Methode zur Empfindlichkeitstestung. Zudem gibt es kaum prospektive Studien für diese Gruppe von Mykobakterien, die eine Korrelation der in vitro erlangten Ergebnisse mit dem Therapieerfolg aufzeigen. Oft scheint der Behandlungserfolg nicht den in vitro ermittelten Sensibilitäten zu entsprechen oder er tritt ein, wenn nach der Resistenzlage nicht damit zu rechnen ist.
Die Ergebnisse mit der konventionellen Proportionsmethode und der automatisierten Empfindlichkeitstestung sind nur schwer reproduzierbar. Für schnell wachsende NTM wird die Durchführung eines Bouillon-Mikroverdünnungstests oder ETest empfohlen.
Nach einem Vortrag von Herrn Priv.-Doz. Dr. med. Jörg Steinmann, Oberarzt im Institut für Medizinische Mikrobiologie am Universitätsklinikum Essen.
Die Autorin:
Ursula Brett, MTA
Uhlenkruggarten 4
45133 Essen
E-Mail: u.brett@arcor.de
Entnommen aus MTA Dialog 11/2015
Dann nutzen Sie jetzt unser Probe-Abonnement mit 3 Ausgaben zum Kennenlernpreis von € 19,90.
Jetzt Abonnent werden
